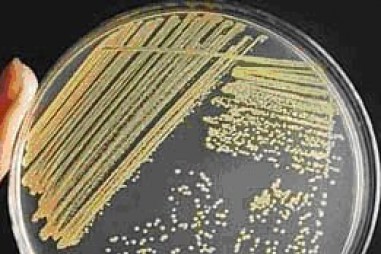
Xác nhận giá trị sử dụng phương pháp thử trong phân tích vi sinh

Bàn giải pháp thúc đẩy xuất khẩu nông lâm thủy sản năm 2025
TNNN - Ngày 12/8, Bộ Nông nghiệp và Môi trường tổ chức 'Hội nghị thúc đẩy xuất khẩu nông lâm thủy sản năm 2025' tại Trung tâm Hội nghị 272 (TP. Hồ...

TNNN - Ngày 12/8, Bộ Nông nghiệp và Môi trường tổ chức 'Hội nghị thúc đẩy xuất khẩu nông lâm thủy sản năm 2025' tại Trung tâm Hội nghị 272 (TP. Hồ...


TNNN - Sau quyết định của Tổ chức Y tế Thế giới và Ủy ban Châu Âu, Novavax trở thành vaccine ngừa COVID-19 dựa trên protein đầu tiên được chấp thuận....

TNNN- Để giải quyết lỗ hổng quan trọng trong việc thử nghiệm nước dằn phù hợp

TNNN - Ngày 27/8, Hội đồng đạo đức trong nghiên cứu y sinh học quốc gia đã chấp thuận kết quả thử nghiệm lâm sàng của vaccine Nanocovax giai đoạn 3a....

TNNN - Các nhà nghiên cứu phát triển một loại bê tông tự vá lành mới chứa enzyme có trong cơ thể người giúp tuổi thọ công trình tăng thêm 20 - 80 năm.

TNNN - Để giải quyết vấn đề ô nhiễm đất tại các bãi tập, bãi chứa bom và các cơ sở quân sự khác, nhóm nghiên cứu tại Đại học York (Anh) đã biến đổi...

TNNN – Cơ quan Quản lý Thực phẩm và Dược phẩm Hoa Kỳ vừa phê duyệt cho phép sử dụng lợn biến đổi gen làm thực phẩm và chữa bệnh cho người.

TNNN - Theo các nhà khoa học Mỹ, biện pháp mới giúp thu nhỏ khối u của bệnh nhân ung thư mà không ảnh hưởng tới các tế bào khỏe mạnh.

TNNN - “Màng lọc tảo hấp thu khí CO2 từ pô xe máy” là một trong những dự án ra đời trước vấn đề ô nhiễm môi trường ngày càng trầm trọng do nhóm sinh...

TNNN - Thuốc Itolizumab của công ty Dược phẩm sinh học Biocon Limited ở Ấn Độ vừa được chấp thuận sử dụng cho những bệnh nhân mắc Covid-19.

TNNN - Vật liệu linh hoạt được gọi là 'vật liệu cực' (polar material) đã được nghiên cứu cả về về lý thuyết và thử nghiệm, được tạo ra trong phòng...

TNNN - Các nhà khoa học Việt bước đầu phát triển hệ dẫn thuốc gọi là "hệ nano tự nhũ hóa" để ứng dụng giúp người bệnh hấp thu dược chất tốt hơn.

TNNN - Tổ chức Y tế Thế giới (WHO) chính thức chấp thuận bộ sản phẩm xét nghiệm nhanh COVID-19 do Việt Nam sản xuất.

TNNN - Một nhóm nhà khoa học Pháp vừa công bố đã thử nghiệm thành công hỗn hợp thuốc chống sốt rét và kháng sinh chống Covid-19.




